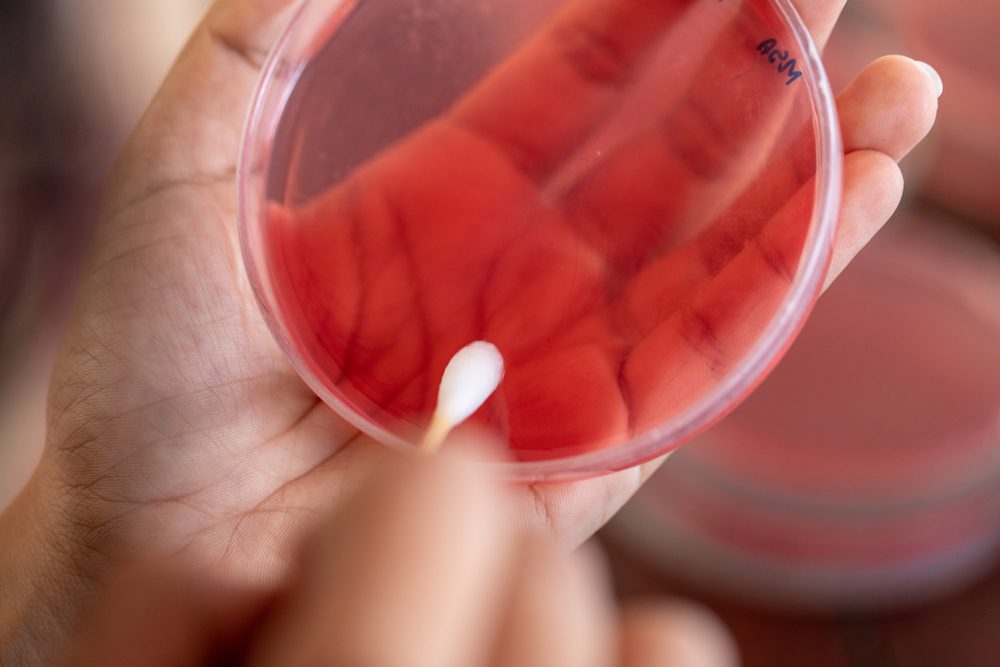
Study for Bacteria (Staphylococcus aureus) in the human nose, for study on Blood Agar Culture Plate in Lab Microbiology.

From STDs to pneumonia to flu, certain infections can increase the risk of heart attack in susceptible people.
13 Common Infections That May Raise Your Heart Attack Risk
The infection-heart connection
There are two major reasons why infections may be linked to heart attacks, says Sean J. Cloonan, MD, internal medicine and infectious disease physician at the Scarsdale Medical Group in New York. The first is that infections cause stress on the body. “And any stress like this can tip somebody over the edge to having a heart attack,” Dr. Cloonan says. “Think of infection as that tipping point.” Second, infections cause inflammation in the body, he explains, which can worsen the process of plaque building up in the arteries. Read on to learn some of the infections that can worsen heart trouble.

Flu
A 2018 study from the London School of Hygiene and Tropical Medicine that was published in The New England Journal of Medicine found that influenza was one of the respiratory illnesses that raised the risk of a heart attack and stroke. Risk increased sharply among the study participants in the first few days after diagnosis. However, receiving the flu vaccine did not increase the risk, so get your flu shot if you can. (Read about how to tell when you have the flu—and when you don’t.)

Bronchitis
Bronchitis is an inflammation of the lining of the lungs that is often caused by an infection, and it can raise the risk of a heart attack or stroke, according to The New England Journal of Medicine study. The researchers found that heart attack risk rose fivefold and stroke risk increased threefold during the first three days following the diagnosis of a respiratory tract infection. The risk declined over time, however, and was nearly normal within three months after people recovered from the infection. (Don’t miss these signs your “cold” is actually something worse.)

Pneumonia
Another problematic respiratory infection: pneumonia. A study in the European Journal of Preventive Cardiology found that patients who had lung infections requiring a hospital admission had a six times greater risk for cardiovascular disease in the year following the illness, compared to people who hadn’t had the infections. And the risk persisted over time: It was more than twice as high for the hospitalized patients two and three years after the event and remained elevated up to five years after. A 2015 study in the Journal of the American Medical Association produced a similar finding. (Be sure you know these silent symptoms of lung disease.)

Other respiratory infections
A study conducted by researchers at Aston Medical School in Birmingham, UK, and presented at the American College of Cardiology conference in 2019 found that respiratory infections could raise the risk of a heart attack and double the risk of a stroke caused by atherosclerosis (the buildup of plaque in the arteries). In fact, researchers said the risk could be greater than the risk posed by obesity and similar to the dangers of high blood pressure and diabetes. (Don’t miss these 7 silent signs you may have clogged arteries.)

Urinary tract infections (UTIs)
UTIs pose a similar heart attack risk. A study in the Journal of the American Heart Association found that one of the most common infections preceding coronary heart disease events and stokes were urinary tract infections, followed by pneumonia, cellulitis (a potentially serious deep tissue infection), and blood infections. And the numbers are striking: 37 percent of people with heart disease developed an infection up to three months before the coronary event. Other research published in Circulation also shows that UTIs are associated with an increased risk of stroke within 29 to 91 days after infection. (These are the 9 symptoms of a urinary tract infection everyone should know.)

Sepsis
Sepsis is an extreme immune system response to an existing infection where the heart and circulatory system begin to fail and blood pressure plummets. This slows blood flow to major organs, which can also begin to fail. People who were hospitalized for this life-threatening condition in the European study were afterward found to have an elevated risk of cardiovascular disease. Researchers say the likely cause is systemic inflammation, which can cause plaque to crack open and potentially lead to a heart attack or stroke. Inflammation remains in the body long after the infection has cleared up, experts say. Don’t miss these signs of sepsis.

Chlamydia
Research has shown that chlamydia, a common sexually transmitted disease, may raise the risk of a heart attack in young men. The lead study author, from the University of Wisconsin, however, cautions that the research is preliminary and further study is needed. Dr. Cloonan agrees: “It’s murky,” he says. “Small studies have been done here and there to try to find a relationship, but they’re not conclusive.” Here are 14 sex problems you should take seriously.

HIV
“It’s very well known that people with HIV have an elevated risk of a heart attack,” says Dr. Cloonan. “This is thought to be related to chronic inflammation.” The virus causes chronic activation of the immune system, which causes molecules called cytokines to circulate and damage the arteries over time. “Some of the older HIV medications also contributed to cardiovascular risk, but we hope the newer drugs will be shown to have less of an effect.” Be sure you know these 13 surprising things about HIV and AIDS.

Oral infections
For reasons that aren’t quite clear, some populations of bacteria inside your mouth can damage your heart. Culprits include tooth infections, gingivitis (swelling of the gums), and periodontitis (which leads to infected pockets of pus). Numerous studies have found a link between periodontal disease and heart disease, according to the American Heart Association. To help prevent this, brush your teeth twice a day, floss daily, see a dentist for cleanings twice a year, and pay prompt attention to any signs of an infected tooth or gum disease. Don’t miss the 13 things dentists never put in their mouths.

Blood infections
“When bacteria get into the blood, that’s a sign that an infection is way out of control,” Dr. Cloonan says. This is known as septicemia and can lead to sepsis. So again, it can lead to an intense response from the immune system and is another example of a situation where your body is in a state of extreme physiological stress. “This can worsen the risk of a heart attack or stroke,” he says. Check out these heart disease risk factors you might not know.

When the heart is infected
Some people develop inflammation in the heart itself—a condition called myocarditis. Myocarditis can be caused by an infection, but also has other causes. Many people with this condition experience no symptoms and recover before they even know they have it. But for others, symptoms may include chest pain; rapid or abnormal heartbeat; shortness of breath; fluid retention in the legs, ankles, and feet; fatigue; and general signs of an infection like headaches, body aches, joint pain, fever, and sore throat, according to the Mayo Clinic. Severe myocarditis weakens the heart and impedes blood circulation. It can also lead to clot formation in the heart, which can lead to a stroke or heart attack.

Viral infections
One of the most common causes of myocarditis is a viral infection. These can include viruses that cause the common cold; hepatitis B and C; parvovirus, which causes a mild rash (usually in children; it’s also known as fifth disease); and herpes simplex virus. Gastrointestinal infections, Epstein-Barr virus (mononucleosis), and German measles (rubella) can also cause myocarditis. People who have HIV/AIDS are also at higher risk of such infections. (Here are the 11 signs of mono you should never ignore.)
Bacterial infections
Numerous other factors can also lead to myocarditis, such as infection with common bacteria like staphylococcus (which causes staph infections) and streptococcus (which causes strep throat, scarlet fever, and other infections). The bacteria that cause diphtheria and the tick-borne bacteria that cause Lyme disease can also be culprits. Check out how doctors can tell whether your infection or viral or bacterial.

Fungal infections
Fungal infections with organisms such as Candida (which can cause yeast infections, UTIs, and throat and skin infections) can sometimes cause myocarditis as well, according to the Mayo Clinic, but that’s more likely in people who have weakened immune systems. It’s important to contact your doctor if you experience any signs of the infection. (Don’t miss these yeast infection symptoms you shouldn’t ignore.)

Taking care of your heart
“We know what the major determinants of heart disease are, including smoking, diabetes, and high cholesterol,” says Dr. Cloonan. “For people who have these risk factors and are on the edge to begin with, getting a bad infection may tip them into having a heart attack.” So it’s important to have your cholesterol checked, maintain healthy blood sugar levels, get screened for diabetes, keep your weight in a normal range, and avoid smoking. “Manage your risk factors to keep yourself as healthy as possible.” He also recommends staying up to date with influenza and pneumococcal vaccines to reduce your risk of these illnesses, as well as the vaccine for rubella. Read on to find out the best and worst diets for heart health.